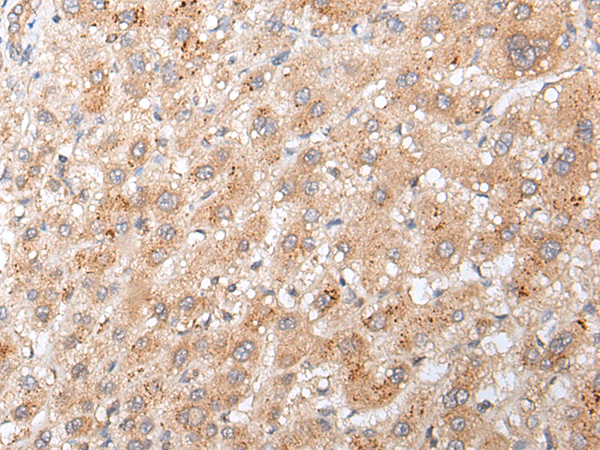

|
Background: |
This gene encodes a nuclear-localized protein that may be induced by p53 and regulates the cell cycle by inhibiting G1 to S phase progression. The encoded protein may interact with other cell cycle regulators. |
|
Applications: |
ELISA, IHC |
|
Name of antibody: |
GADD45GIP1 |
|
Immunogen: |
Synthetic peptide of human GADD45GIP1 |
|
Full name: |
growth arrest and DNA-damage-inducible, gamma interacting protein 1 |
|
Synonyms: |
PRG6; CRIF1; PLINP; CKBBP2; Plinp1; MRP-L59; PLINP-1; CKbetaBP2 |
|
SwissProt: |
Q8TAE8 |
|
ELISA Recommended dilution: |
5000-10000 |
|
IHC positive control: |
Human liver cancer and human tonsil |
|
IHC Recommend dilution: |
25-100 |

購物車
幫助
021-54845833/15800441009
